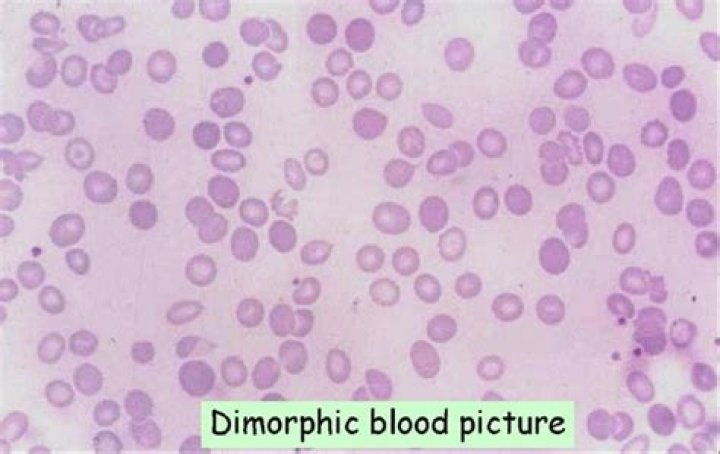
Cover

What is dimorphic blood picture?
A dimorphic blood film is an important clue to a diagnosis of congenital or acquired sideroblastic anemia. However there are other more common causes, including the treatment of iron deficiency anemia, and blood transfusion in patients with a hypochromic microcytic anemia.
What is the meaning of dimorphic anemia?
DEFINITION. Dimorphic anaemia is an anaemia which is due to two deficiencies, iron- deficiency and that of nutritional macrocytic anaemia. It is thus iron-deficiency anaemia complicated by nutritional macrocytic anaemia or may equally well be regarded as nutritional macrocytic anaemia complicated by iron-deficiency.
What causes dimorphic anemia?
Dimorphic anemia is mainly caused due to two deficiencies, iron-deficiency, and nutritional macrocytic anemia. It is, therefore, iron-deficiency anemia complicated by nutritional macrocytic anemia or may be regarded as vice versa condition.
What is the interpretation of MCV when there is presence of dimorphic population of RBC?
MCV, as well as MCH and MCHC, reflect average values and may not adequately reflect RBC changes where mixed RBC populations are present, such as dimorphic RBC populations in sideroblastic anemia or combined iron deficiency anemia (decreased MCV and MCH) and megaloblastic anemia (increased MCV).
What are 3 types of anemia?
Types
- Aplastic anemia.
- Iron deficiency anemia.
- Sickle cell anemia.
- Thalassemia.
- Vitamin deficiency anemia.
What is MCV in blood test if high?
An average MCV score is between 80 and 95. If the MCV goes up to an extreme of 125, it may indicate vitamin B12, folate deficiencies, or cold agglutinin disease. A higher MCV value indicates that the red blood cells are larger than the average size.
What does dimorphic mean in genetics?
Dimorphism. Having two different distinct forms of individuals within the same species or two different distinct forms of parts within the same organism.